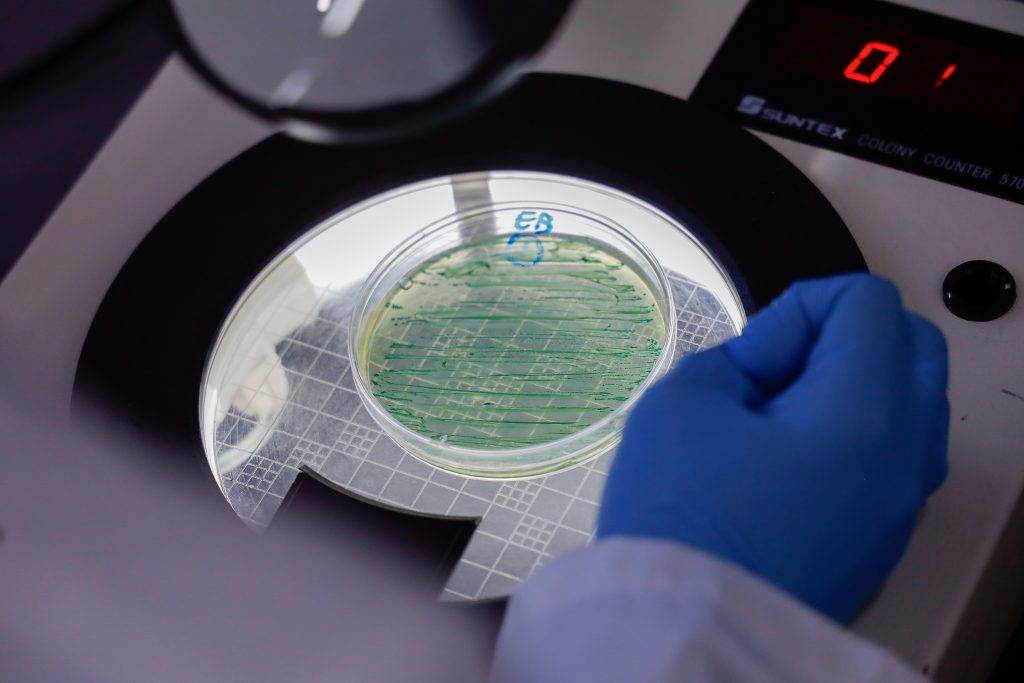

La Política de Acceso Abierto ANID busca asegurar la disponibilidad del conocimiento científico contenido en las publicaciones, tesis, datos de investigación resultantes de la ejecución de proyectos de investigación financiados con recursos públicos. Más información en: https://acceso-abierto.anid.cl/
Rutas de Acceso Abierto para publicaciones

Ruta verde al Acceso Abierto:
El autor deposita la versión aceptada de su artículo en un repositorio institucional o temático. Se debe esperar un período de embargo, que puede variar entre 6 y 24 meses, antes de que la publicación esté disponible públicamente.

Ruta dorada al Acceso Abierto:
Implica el acceso público, inmediato, permanente y gratuito al artículo final. Ello se consigue mediante el pago de una tarifa variable conocida como APC (Article Publishing Charge), que son los costos derivados del proceso de revisión, producción y publicación del artículo que cobran las editoriales.